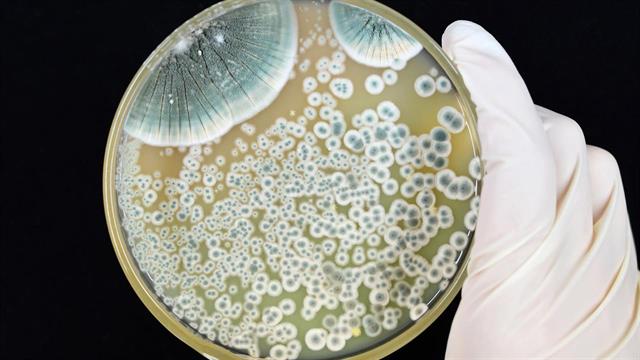
Σοβαρές ελλείψεις σε πενικιλίνη καταγράφονται στις ΗΠΑ

Ο Οργανισμός Τροφίμων και Φαρμάκων των ΗΠΑ (FDA) ανέφερε έλλειψη μιας ενέσιμης μορφής πενικιλίνης, ενός αντιβιοτικού που χρησιμοποιείται για τη θεραπεία της σύφιλης και άλλων βακτηριακών λοιμώξεων, όπως ο στρεπτόκοκκος λαιμού.
Το φάρμακο προστίθεται σε έναν αυξανόμενο κατάλογο φαρμάκων που αντιμετωπίζουν ελλείψεις στις ΗΠΑ, όπως η υγρή αμοξικιλλίνη, η οποία βρίσκεται σε έλλειψη από τον Οκτώβριο.
Η μορφή της επηρεασμένης πενικιλίνης, που ονομάζεται πενικιλίνη G βενζαθίνη, είναι το προτιμώμενο φάρμακο για τη σύφιλη, επειδή μπορεί να χρησιμοποιηθεί σε ενήλικες, παιδιά και εγκύους. Συχνά χορηγείται σε εξωτερικά ιατρεία ή σε χώρους επείγουσας φροντίδας. Οι δόσεις τόσο για παιδιά όσο και για ενήλικες είναι ελλιπείς, σύμφωνα με την ανακοίνωση από τον FDA.
Τα κρούσματα σύφιλης στις ΗΠΑ έφτασαν σε υψηλό 70 ετών το 2021, το τελευταίο έτος για το οποίο υπάρχουν διαθέσιμα στοιχεία, σύμφωνα με τα Κέντρα Ελέγχου και Πρόληψης Νοσημάτων. Η σεξουαλικά μεταδιδόμενη λοίμωξη μπορεί να οδηγήσει σε βλάβη οργάνων ή ακόμη και σε θάνατο εάν αφεθεί χωρίς θεραπεία.
Ο FDA απέδωσε την έλλειψη πενικιλίνης στην αυξημένη ζήτηση. Η Pfizer, ο μοναδικός προμηθευτής αυτής της μορφής πενικιλίνης στις ΗΠΑ, επεσήμανε την έλλειψη αμοξικιλίνης ως το κύριο ζήτημα, επειδή ώθησε τους γιατρούς να συστήσουν αντ' αυτού πενικιλίνη. Η έλλειψη αμοξικιλλίνης προέκυψε κατά τη διάρκεια μιας έξαρσης λοιμώξεων από ιούς του αναπνευστικού το Φινόπωρο και τον Χειμώνα, όταν το αντιβιοτικό συνταγογραφήθηκε για δευτερογενείς βακτηριακές λοιμώξεις που προέρχονται από τον Covid, τη γρίπη ή τον αναπνευστικό συγκυτιακό ιό.
Οι αριθμοί κρουσμάτων στρεπτόκοκκου στο λαιμό παραμένουν αυξημένοι. Το CDC είπε την περασμένη εβδομάδα ότι αδημοσίευτα δεδομένα από το εθνικό πρόγραμμα επιτήρησης έδειξαν υψηλό πενταετίας στις επισκέψεις στα επείγοντα περιστατικά για τακτικές λοιμώξεις από στρεπτόκοκκο τον Φεβρουάριο και τον Μάρτιο.
Ο FDA ανέφερε στον ιστότοπό του ότι τα προβλήματα εφοδιασμού αναμένεται να επιλυθούν κάποια στιγμή από τον Οκτώβριο έως τον Δεκέμβριο.
Πηγές:
nbcnews.com
Ειδήσεις υγείας σήμερα
Εμβόλιο κατά του καρκίνου του εγκεφάλου δείχνει θετικά αποτελέσματα
Όταν χάνει η ομάδα: Πώς να μην πέσουμε σε θλίψη ως φίλαθλοι
Περιοδεία ΠΑΣΟΚ σε δομές Υγείας με αιχμή τις ελλείψεις προσωπικού
Διεισδυτικός στρεπτόκοκκος: Μειούμενη τάση μετά την έξαρση
Διεισδυτικός στρεπτόκοκκος: Μειούμενη τάση μετά την έξαρση Στρεπτόκοκκος ομάδας Α: Διάγνωση, αντιμετώπιση, σημεία προσοχής
Στρεπτόκοκκος ομάδας Α: Διάγνωση, αντιμετώπιση, σημεία προσοχής Ο στρεπτόκοκκος πάει σχολείο! Τι να ξέρετε, χωρίς να τρέξετε στο Google Search με πανικό!
Ο στρεπτόκοκκος πάει σχολείο! Τι να ξέρετε, χωρίς να τρέξετε στο Google Search με πανικό! Διεισδυτική στρεπτοκοκκική λοίμωξη: Ραγδαία αύξηση στην πανδημία [μελέτη]
Διεισδυτική στρεπτοκοκκική λοίμωξη: Ραγδαία αύξηση στην πανδημία [μελέτη] Στρεπτόκοκκος - Ομοσπονδία Παιδιάτρων: Δεν πρέπει να κλείνουν τα σχολεία
Στρεπτόκοκκος - Ομοσπονδία Παιδιάτρων: Δεν πρέπει να κλείνουν τα σχολεία ΕΟΔΥ: Οδηγίες προστασίας από στρεπτόκοκκο στο σπίτι και στο σχολείο
ΕΟΔΥ: Οδηγίες προστασίας από στρεπτόκοκκο στο σπίτι και στο σχολείο Όταν χάνει η ομάδα: Πώς να μην πέσουμε σε θλίψη ως φίλαθλοι
Όταν χάνει η ομάδα: Πώς να μην πέσουμε σε θλίψη ως φίλαθλοι Η εντατική ενασχόληση με τα βιντεοπαιχνίδια δεν μειώνει τις γνωστικές ικανότητες (Μελέτη)
Η εντατική ενασχόληση με τα βιντεοπαιχνίδια δεν μειώνει τις γνωστικές ικανότητες (Μελέτη) Ο EMA επιταχύνει την αξιολόγηση ενός φαρμάκου για τον μεταστατικό καρκίνο του παγκρέατος
Ο EMA επιταχύνει την αξιολόγηση ενός φαρμάκου για τον μεταστατικό καρκίνο του παγκρέατος Μικροβιακή αντοχή: Τέσσερις φυσικές ουσίες μπλοκάρουν το ζωτικό "καύσιμο" των βακτηρίων
Μικροβιακή αντοχή: Τέσσερις φυσικές ουσίες μπλοκάρουν το ζωτικό "καύσιμο" των βακτηρίων Pfizer: Νέα ιατρική διευθύντρια η Χριστίνα Μιχαηλίδη
Pfizer: Νέα ιατρική διευθύντρια η Χριστίνα Μιχαηλίδη Ιδέες για πρωινό με πολλή πρωτεΐνη
Ιδέες για πρωινό με πολλή πρωτεΐνη Παχυσαρκία: Τι σημαίνει για τους ασθενείς η διακοπή του "Προλαμβάνω"
Παχυσαρκία: Τι σημαίνει για τους ασθενείς η διακοπή του "Προλαμβάνω" Pharmathen: Αναδιάρθρωση χρέους έως 664,5 εκατ. ευρώ, που θωρακίζει τους δανειστές
Pharmathen: Αναδιάρθρωση χρέους έως 664,5 εκατ. ευρώ, που θωρακίζει τους δανειστές Συνελήφθη αγροτικός γιατρός στο Καστελόριζο - Γεωργιάδης: Είχε διαφορές με την τοπική κοινωνία
Συνελήφθη αγροτικός γιατρός στο Καστελόριζο - Γεωργιάδης: Είχε διαφορές με την τοπική κοινωνία Οπτικοί: Άμεση ανάκληση των εγκυκλίων για τα γυαλιά ηλίου
Οπτικοί: Άμεση ανάκληση των εγκυκλίων για τα γυαλιά ηλίου "Προλαμβάνω" - Παχυσαρκία: Προβλήματα σε ασθενείς από την ολοκλήρωση του προγράμματος
"Προλαμβάνω" - Παχυσαρκία: Προβλήματα σε ασθενείς από την ολοκλήρωση του προγράμματος 9 εξακριβωμένα οφέλη του κολοκυθόσπορου
9 εξακριβωμένα οφέλη του κολοκυθόσπορου